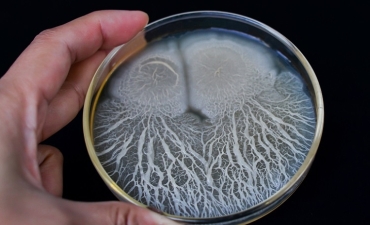
7 tác dụng của Bacillus subtilis trong nuôi trồng thủy sản

ẾCH BỐ MẸ
Đầu tiên phải chọn ếch bố mẹ khỏe mạnh, không nhiễm nấm, khuẩn. Và quan trọng là không được lấy ếch đực, ếch cái cùng một nơi để tránh tình trạng cận huyết. Tỷ lệ cho ghép đôi thường là 1:1, mỗi cặp 1m2, thế nhưng một mẹo nhỏ là cứ hễ 10 cặp thì nên cho thêm vào khoảng 1 hoặc 2 con ếch đực để tăng tỷ lệ thụ tinh. Đối với những con cái không muốn đẻ thì việc bổ sung thêm ếch đực này sẽ “ép” ếch cái bắt buộc phải giao phối và đẻ trứng.
Để xác định thời gian ếch cái chuẩn bị đẻ, người ta thường dựa vào những đặc điểm bên ngoài. Phần bụng ếch cái to và mềm hơn bình thường, khi sờ xung quanh sườn, dưới mang bị sần, không còn trơn láng như trước. Ếch đực thì phồng mang, kêu liên tục. Những điều này là dấu hiệu để nhận biết ếch cái đã sẵn sàng đẻ trứng. Nên dùng thuốc kích thích vừa đủ ở lứa đẻ đầu, các lứa tiếp theo chỉ nên dùng 1 ít thuốc. Vì quá nhiều thuốc có thể làm ếch cái “ra” cả trứng non.
Để thuận theo tự nhiên, thì người nuôi nên cho ếch đực và ếch cái “hẹn hò” lúc 6 giờ chiều. Như vậy thì ngay buổi tối đó chúng sẽ giao phối với nhau. Sau đó ếch cái sẽ đẻ trứng ngay tại bể.
CHÚ Ý KHI ƯƠNG TRỨNG
Sáng hôm sau khi ếch đã đẻ, khoảng 7 giờ đưa ếch bố mẹ ra khỏi bể đẻ để ương trứng. Trứng ếch hình cầu, đường kính 1.5-1.8mm, bên ngoài trứng có một màng nhầy trong suốt bao bọc, màng này ngoài chức năng bảo vệ trứng thì còn làm tăng điểm hội tụ ánh sáng, nâng nhiệt độ của trứng lên để nở nhanh hơn. 20-25oC là nhiệt độ thích hợp cho trứng nở, khi nhiệt độ lớn hơn 35oC sẽ làm trứng bị ung, hỏng.

CÁC ĐIỀU KIỆN PHÙ HỢP
Ban đầu trước khi cho ếch vào giao phối, mực nước trong bể là 2-5cm. Nhưng sau khi đưa ếch bố mẹ ra khỏi bể thì mực nước phải được nâng lên từ từ 10-15cm. Việc tăng mực nước lên dần trong nhiều ngày liền sẽ tạo dưỡng khí trong nước giúp trứng mau nở và nòng nọc nhanh lớn hơn.
Bể đẻ phải được vệ sinh sạch sẽ và vô trùng nước kỹ càng để tránh tác động tiêu cực đến trứng và nòng nọc. Nước cho ếch đẻ không sạch thì trứng sẽ hỏng. Khi ếch đã thành nòng nọc thì độ đục trong ao cần phải ổn định. Việc tạo mưa nhân tạo hoặc làm lạnh bằng nước đá cũng sẽ giúp ếch đẻ nhiều đợt hơn trong năm.
Tuyệt đối không thay nước trong 4 ngày đầu, sau đó thì có thể thay nước nhưng không quá ⅓ mực nước trong bể vì phải đảm bảo cho sự ổn định trong thời gian nhạy cảm này. Khi có thể thay nước thì mực nước không thấp hơn 7-8cm. Vì khi trứng đã nở thành nòng nọc thì chúng rất thích ngoi lên ngoi xuống mặt nước để thở. Nếu mực nước quá cao thì nòng nọc sẽ tốn rất nhiều thời gian cho hoạt động này và làm hạn chế sự tăng trưởng của chúng.
THỨC ĂN CHO ẤU TRÙNG
Ban đầu nòng nọc sống bằng noãn hoàng từ 2-3 ngày, sau đó tự bơi đi kiếm ăn. Thức ăn tiếp theo là động vật phù du, bột cám gạo hay tôm khô nghiền nhỏ. Cho ăn ngày 3 bữa, sau khi cho ăn 15 phút nên kiểm tra lượng thức ăn để có sự điều chỉnh cho phù hợp.
Đặc biệt, có thể cho nòng nọc ăn thêm lòng đỏ trứng gà hoặc lòng đỏ trứng vịt luộc. Luộc 4 trứng/10.000 con, ăn 2 cử sáng chiều. Lưu ý khi luộc phải vừa chín tới, không để quá chín hoặc quá sống, khuấy tan lòng đỏ ra nước. 5-7 ngày sau giảm lượng lòng đỏ trứng đi từ từ rồi bắt đầu cho ăn thức ăn hỗn hợp. Độ đạm của các loại thức ăn này phải lớn hơn 40%.
Nòng nọc ở giai đoạn 10 ngày tuổi có thể xảy ra sự phân đàn, lớn không đều, tranh giành thức ăn với nhau. Do đó, giai đoạn này nên phân cỡ để nuôi riêng, tránh hao hụt. Đến khi nòng nọc cụt đuôi, di chuyển tốt (25-30 ngày sau khi nở), trọng lượng đạt 300-500 con/kg thì có thể đưa ra bể khác để bắt đầu nuôi thương phẩm.
Nguồn An Binh Biochemistry

 Facebook
Facebook  Youtube
Youtube